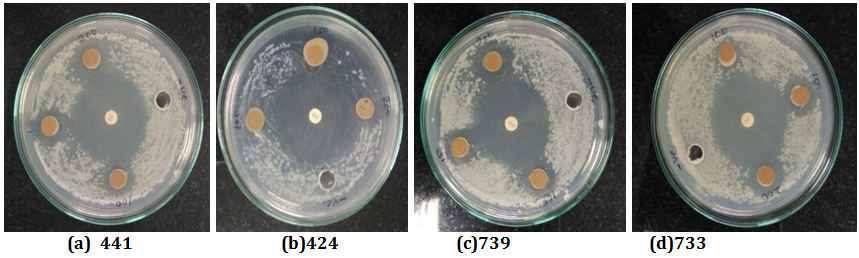
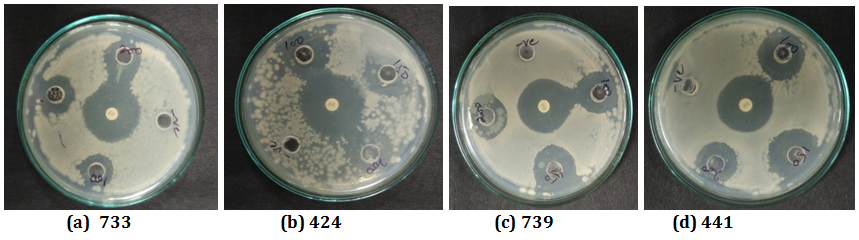

Department of Biotechnology, Govind Ballabh Pant Engineering College, Pauri Garhwal, Uttarakhand, India 246194
Email: ajeetsoniyal@gmail.com
Received: 20 Mar 2016, Revised and Accepted: 20 Jun 2016
ABSTRACT
Objective: To screen and isolate the antibacterial proteins/peptides from seeds of millets.
Methods: Present study was designed to investigate antibacterial activity of proteins/peptides extracted from seeds of different varieties of millet (Finger Millet (PRM I, PRM II), Barnyard millet and Proso millet). The extracted proteins/peptides were checked for antibacterial activity against Bacillus subtilis (MTCC 441), Pseudomonas aeruginosa (MTCC 424), Escherichia coli (MTCC 733) and Salmonella entrica (MTCC 739) bacterial pathogens.
Results: Results indicated that finger millet variety (PRM I) has showed the highest antibacterial activity against P. aeruginosa and S. entrica with a zone of inhibition 22.6±1.18 and 22.3±0.98 respectively. The seed extract of Proso millet has shown the least activity with the gram-positive bacteria with a zone of inhibition 15.6±0.27 mm. The finger millet variety (PRM I) with a molecular weight of 35kDa showed the highest antibacterial activity against Pseudomonas aeruginosa with a zone of inhibition 19 mm.
Conclusion: Millet, a widely growing cereal crop in semi-arid regions, has been known for its medicinal importance to cure fungal and bacterial infections. Results obtained in the present study suggest that antibacterial peptides may be used as potential alternatives for the development of novel antibacterial agents.
Keywords: Millets, Antimicrobial peptides (Amps), Antibacterial Proteins/peptides, Antibacterial activity, SDS-Page
© 2016 The Authors. Published by Innovare Academic Sciences Pvt Ltd. This is an open access article under the CC BY license (http://creativecommons.org/licenses/by/4.0/)
INTRODUCTION
Antimicrobial peptides (Amps) are small glycine and cysteine-rich amino acid residues of polypeptides known as "host defense peptides" and are part of the innate immune response found among all classes of life. Antimicrobial proteins/peptides have a molecular weight of 4-50kDa, which plays a role in the defense of the plant immune system, also inhibit various fungal and bacterial infections. By attacking the cell membrane of different bacterial and fungal species, they help the plants from adverse damaged caused by various species and prevent economic losses. Antimicrobial peptides have been isolated from seeds, roots, leaves, flowers and stems of plant species and their activities have been evaluated against phytopathogens, as well as pathogenic microorganisms such as parasites, bacteria, viruses, fungi and neoplastic cells [1]. The germination stages of plant seeds have also played a major role in the secretion of Amps. Before germination, because of effective physical barriers (hard coat and low water content), plant seeds are effective against fungal and bacterial invasion. During germination, the protection is mainly lean upon the secretion of antimicrobial compounds together with protein [2, 3]. In the last decade, several categories of proteins and peptides with antimicrobial properties have been discovered. These includes chitinase [4, 5], permatins [6], defensins [7, 8], β-l,3-glucanases [9], ribosome-inactivate proteins [4, 10], thionins [11], chitin-binding lectins and non-specific lipid transfer protein [12].
Human pathogens mainly bacteria have developed resistance against some of the available antibiotics resulting their decreasing efficacy. To find out the solution of this problem is a challenge in medical science. Therefore, we need to find natural antibacterial agents in the treatment of bacterial infection. In the present study, we have selected the three varieties of millet seeds for the screening and isolation of antibacterial proteins/peptides. Recent studies have shown that millets contain a wide variety of proteins. Millets are mainly small-seeded grain and warm weather cereals. As previously reported studies, Millets acquire unique position among grass family (Paniceace/Gramineae) and also referred to as nutri-cereals, and are rich in nutritional quality and have vast health benefits. Millets are the cereal crop and important food staple in different countries. Millet is a C4 plant which means it utilizes high temperature and has good water efficiency. It is a rich source of vitamin, protein, calcium and dietary fibers.
Finger millet is widely grown as a cereal crop and grains for fodder. From the four major crops widely grown, the finger millet is the most commonly used cereal crop grown in semi-arid regions. Finger millet is also known as ‘Ragi.' In human history, Finger millet is the most important food staple and belongs to the family of Eragrostideae tribe. The millet contains 6-8% protein, 1-1.7%fat, 18-20% dietary fiber and 2-2.5% minerals [13]. Seeds mainly contain high quantity of proteins. Finger millet is nutritionally superior to many of the major cereals and offers several health benefits.
Proso millet belongs to the family of Poaceae. Proso millet (Panicum miliaceum) is the most widely grown cereal crop in Asian countries and has various health benefits, reduces the risk of chronic disease. The millet contains 12 % protein, 4% fat, 8% calcium, 5.2% crude fiber and 2% minerals [14].
Baryard millet also belongs to the family of Poaceae. Branyard millet (Echinochloa frumentacea) is another variety of millet which is widely grown in India, Pakistan and Nepal. It is cultivated on marginal land where other crops will not grow well. The millet contains 11.2% protein content, 4% fat, 10-11% fiber and 4-4.5% minerals.
In the present study, we have chosen some of the varieties of millets such as Finger millet (PRM I and PRM II), Proso millet and Barnyard millet. These plants can be used to discover bioactive natural products in the form of antimicrobial proteins and peptides that may serve for the development of new pharmaceuticals. Such screening of various natural antimicrobial proteins and peptides supports the traditional knowledge of local users and it is a preliminary scientific validation for the use of these plants for the antibacterial activity [15]. Previously studies reported that foxtail millet seeds have antifungal peptide with a molecular mass of 26.9 kDa. As these varieties of millets are highly rich in polyphenolic contents and are considered most important phytochemicals in millets and possesses nutraceutical potential such as antioxidant activity, anti-inflammatory, anticarcinogenic, antimicrobial, anti-diarrheal, anti-ulcer and anti-cardiovascular properties [16]. So, we have chosen the seeds of millet for the screening and isolation of antibacterial protein/peptides.
MATERIALS AND METHODS
Sample collection
Seeds of Proso millet, Barnyard millet and Finger millet (PRM I and PRM II) were collected from University of Horticulture and Forestry, Ranichauri and was authenticated by the taxonomist of Department of Botany, HNB University Srinagar, Uttarakhand.
Bacterial strains
All the bacterial strains used in this study were collected from Microbial Type Culture Collection (MTCC), Institute of Microbial Technology (IMTECH), Chandigarh, India. The bacterial strains includes Bacillus subtilis (MTCC 441), Pseudomonas aeruginosa (MTCC 424), Escherichia coli (MTCC 733), Salmonella entrica (MTCC 739). The cultures were stored at 4 °C and sub-cultured at regular intervals.
Sample preparation
Fresh seeds of different varieties of millets were collected and rinsed with 0.1% of sodium hypochlorite solution for 10 min and then washed with distilled water for the removal of dirt and debris. After that, seeds were dried under sterile conditions and then using liquid nitrogen, seeds were ground to fine powder in pre-chilled mortar and pestle followed by extraction in Tris-HCl (pH-8.0) buffer for the isolation of crude protein [17].
Protein extraction method
Proteins were extracted from seed flour in 0.1 M Tris/HCl and 0.5 M NaCl(pH 8.0) for 2 hr. After that spin at 12000rpm for 20 min. The supernatant was collected for further use in gel electrophoresis. Protein concentrations of all the samples were measured by the protein dye-binding method of Bradford at 595 nm using BSA as a standard [18].
SDS-page
SDS-PAGE was performed according to the method described by Laemmli [19] using a Bio-rad Mini PROTEAN Cell electrophoresis apparatus. The sample buffer contained (0.125 M Tris pH 6.8, 2.5% SDS, 20% glycerol, 0.002% Bromophenol blue, 10% β-mercaptoethanol). After the run, the gel was removed from plates and put in staining solution (0.1% Coomassie brilliant blue R-250 w/v in 40% methanol, 10% acetic acid v/v) for 4-6 h with mild shaking at room temperature. Then, the gel was destained with several changes of destaining solution I (40% methanol, 10% glacial acetic acid) and finally kept in destain II (10% glacial acetic acid).
After the Gel-electrophoretic procedure, the gel was cut into pieces and the protein was eluted from the gel matrix with the gel elution buffer pH-7.5. After immersing the gel pieces in elution buffer, the sample is centrifuged at 10,000 rpm for 10 min at 4 °C. The supernatant containing the isolated protein/peptide was further analyzed for antibacterial activity.
Antibacterial assay
Antibacterial activity of a protein from seed samples was done against bacterial pathogens such as E. coli, Salmonella entrica, Pseudomonas aeruginosa, Bacillus subtilis by using Agar well diffusion method [20]. The strain of each bacterium was swabbed on to the petri plates having Nutrient Agar media. Wells were made by the help of borer. Solutions of isolated proteins were loaded onto each well of different concentration of 100 µl, 150 µl and 200 µl and incubate at 37 °C for 24 h. Then zones of inhibition were measured, and the assays were performed in triplicate.
RESULTS AND DISCUSSION
Various Plant antimicrobial peptides have been reported till date for the treatment of various human ailments. The wide variety of antimicrobial proteins/peptides has vast properties such as antioxidant, anti-inflammatory, anti-cancerous and antimicrobial activities [21]. Nowadays, as there is a huge increase in human diseases, they can be cure by antimicrobial peptide antibiotics replacing the need of conventional antibiotics. Several Antimicrobial proteins/peptides have been reported, purified and characterized by using a large variety of techniques like RP-HPLC, ion exchange chromatography those are quite expensive and time-consuming. Herein, we have isolated the Antibacterial proteins/peptides from millet varieties by cost effective and time-saving methods.
Importantly, this approach allows us to detect antibacterial activities in Millet seeds protein. Altogether, the results indicate that millet proteins are rich sources for the production of bioactive peptides with antibacterial properties.
Antibacterial assay of crude protein extracts result
The results of Antibacterial activity of three varieties of millet seeds extracts were prepared in Tris-HCl buffer (pH-8.0) was tested against gram positive and gram negative bacteria which were studied. Among all the crude protein seed extracts, Barnyard millet showed no inhibitory activity against all the bacterial strains. The other two varieties of millet showed good inhibitory results in both grams positive and gram negative bacterial strains. As shown in table 1, finger millet seeds extract (PRM I), the highest activity has shown against P. aeruginosa and S. entrica with a zone of inhibition 22.6±1.18 and 22.3±0.98 respectively.
In the PRM II variety of finger millet, no inhibitory activity has shown in any of the bacterial strain. The seed extract of Proso millet has shown the least activity with the gram-positive bacteria with a 15.6±0.27 mm zone of inhibition.
Table 1: Diameter of zone of inhibition of different plant seed crude protein extracts
| S. No | Plant name | E. coli (733) |
Bacillus subtilis(441) | Pseudomonas aeruginosa(424) | Staphylococcus aureus(739) | Antibiotic (tetracylin) |
| 1. | Finger millet(PRM I) | 18.6±0.72 | 21.3±0.72 | 22.6±1.18 | 22.3±0.98 | 13 |
| 2. | PRM II | - | - | - | - | 13 |
| 3. | Proso millet | 20±0.47 | 15.6±0.27 | 17±0.47 | 18.6±0.72 | 13 |
| 4. | Barnyard millet | - | - | - | - | 13 |
SDS-Page analysis of crude protein extract
The total protein concentrations of all the samples were estimated by Bradford method. The highest concentration of protein was observed in Proso millet of about 420µg/ml and Finger millet (PRM I) of about 323µg/ml protein content and the least in the Barnyard millet. On the basis of spectrophotometric results, the 50µg of crude protein was loaded onto 12% SDS-Page. The molecular weight profile of different samples was observed and indicated the presence of proteins with a molecular weight ranging from 8 kDa-245 kDa, in accordance with the previously reported studies [22-24].
The protein bands observed in this study was further analyzed for the antibacterial activity.

Fig. 1: SDS-Page analysis of crude protein extract: 1. shows the molecular marker, 2. Finger millet seed extract (PRM I), 2. Proso millet seed extract
Fig. 2: Antibacterial activity of proso millet against bacterial strains (a) B. subtilis (441) (b) P. aeruginosa (424) (c) S. entrica (739) (d) E. coli(733)
Fig. 3: Antibacterial activity of finger millet against bacterial strains (a) E. coli (733) (b) P. aeruginosa (424) (c) S. entrica (739) (d) B. subtilis (441)
Antibacterial activity of gel cut-off bands
Furthermore, among the gel electrophoresis results of all three different varieties of millet, only the finger millet variety (PRM I) with a molecular weight of 35kDa showed the highest antibacterial activity against Pseudomonas aeruginosa with a zone of inhibition 19 mm. As the Barnyard millet and PRM II had not shown any antibacterial activity with crude protein seed extract, it was not further analyzed for SDS-Page.
Statistical analysis
The results of antibacterial activity of different samples were carried out in triplicate. The zone of inhibition were expressed in mm and were analyzed by ANOVA which was considered significant when p<0.05.
CONCLUSION
In the present study, we have used the three varieties of millets for screening and isolation of antibacterial proteins and peptides by using very simple and cost effective methods. From our work we have conclude that the isolated protein and peptide showed antibacterial activity against pathogenic gram positive and gram negative bacteria which may serve as new antibacterial agent in future. These plants antibacterial protein/peptide play an important role in first line defense in plant immune system.
Moreover, such screening of antibacterial protein/peptide those are isolated from plant seeds plays an important role in the treatment of a bacterial infection that are currently difficult to treat with currently available techniques and hence we can use this as a new medicine for the same for better effect.
ACKNOWLEDGEMENT
This study was conducted in the Department of Biotechnology, G. B. Pant Engineering College (GBPEC), Pauri Garhwal (Uttarakhand). Authors gratefully acknowledge the necessary instrumental facilities, consumables and constant supervision provided by the Department of Biotechnology, Govind Ballabh Pant Engineering College, Pauri Garhwal, Uttarakhand, India. Anjali Bisht and Manisha thapliyal are thankful to TEQIP for providing the financial assistantship.
CONFLICT OF INTERESTS
Declare none
REFERENCES
How to cite this article